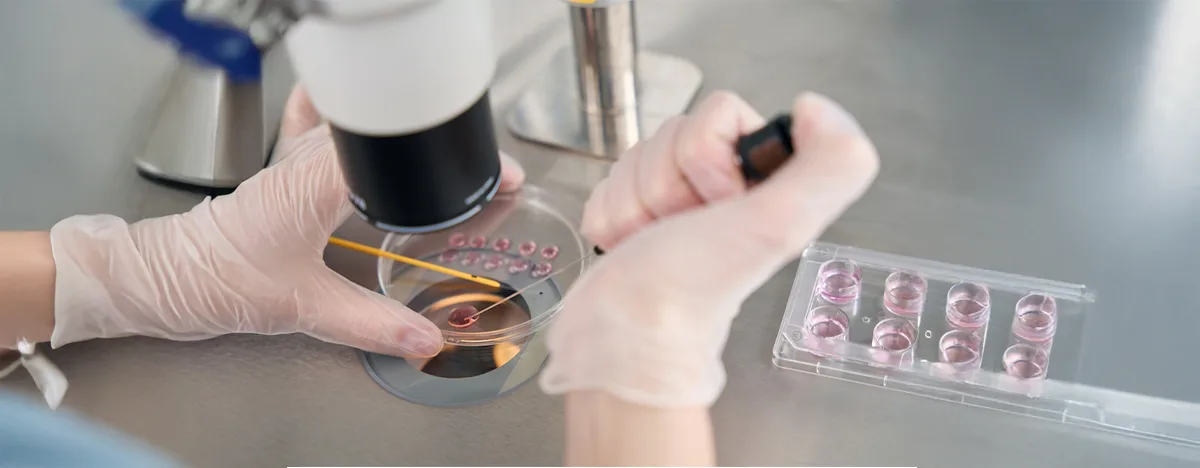
EmbriyoGlue

EmbryoGlue (Embriyo Yapıştırıcı) Nedir?
EmbryoGlue yöntemi tüp bebek laboratuvarında kullanılan bir tür kültür ortamıdır. Embriyologlar laboratuvarda embriyoları geliştirirken, gelişmekte olan embriyolara gelişmeleri ve bölünmeleri için ihtiyaç duydukları besi ortamını sağlarlar.
EmbryoGlue, bildiğiniz gibi bir yapıştırıcı değildir; embriyoların hastanın rahmine transferiden hemen önce bırakıldığı hyaluronan adı verilen bir madde ile zenginleştirilmiş bir tür sıvı embriyo kültürü ortamıdır.
Hyaluronan, vücudun tüm dokularında bulunan doğal bir karbonhidrattır. Embriyonun düzgün bir şekilde gelişmesi için ihtiyaç duyduğu karbonhidratlar, amino asitler ve protein açısından zengindir. Ayrıca embriyonun rahim içinde hareket kabiliyetini azalttığı için embriyo yapıştırıcısı diye isimlendirilir.
Embriyo transferinden hemen önce embriyoları EmbryoGlue’ya daldırarak İmplantasyon sırasında rahimdeki hyaluronan düzeylerinin artması nedeniyle gebelik şansını önemli ölçüde artırdığı ve canlı doğum oranında artış sağladığı düşünülmektedir.
2014 yılında yayınlanan ve 3898 kadından oluşan araştırmaları içeren bir makalede, IVF tedavisi sırasında yüksek konsantrasyonlarda hyaluronan ile desteklenmiş besiyerlerinin kullanımının gebelik ve canlı doğum oranlarını %8’e kadar önemli ölçüde artırdığı sonucuna varmıştır.
Tüp bebekte en önemli adımlardan biri embriyo transferidir. EmbryoGlue ile embriyolarınıza yardım eli uzatın.
EmbryoGlue (Embriyo Yapıştırıcı) Nasıl Uygulanır?
Embriyolarınız 3-5 gün laboratuvar inkübatöründe geliştirildikten sonra embriyo transferi için en uygun olanı seçilir. Transfer için seçilen embriyolar EmbryoGlue içine yerleştirilir ve embriyo transfer noktasına kadar 30 dk bu özel kültür ortamında bekletilir. Bu işlemden sonra embriyolar kültür kabından alınır ve kateter adı verilen ince bir tüpe çekilir. Kateter daha sonra ultrason rehberliğinde rahim ağzından geçirilir ve embriyolar rahme aktarılır.
Yan Etkileri ve Riskleri Nelerdir?
EmbryoGlue kullanımından kaynaklanan bilinen bir risk yoktur. Araştırmalarda, düşük riskini ya da hamilelik komplikasyonlarını artırmadığı gösterilmiştir.
EmbriyoGlue Kimlere Uygulanır?
- Tekrarlayan tüp bebek başarısızlığı
- 35 yaş üzeri hastalarda
- Yumurta veya sperme bağlı embriyo kalitesinin iyi olmadığı durumlarda kullanılmaktadır.

